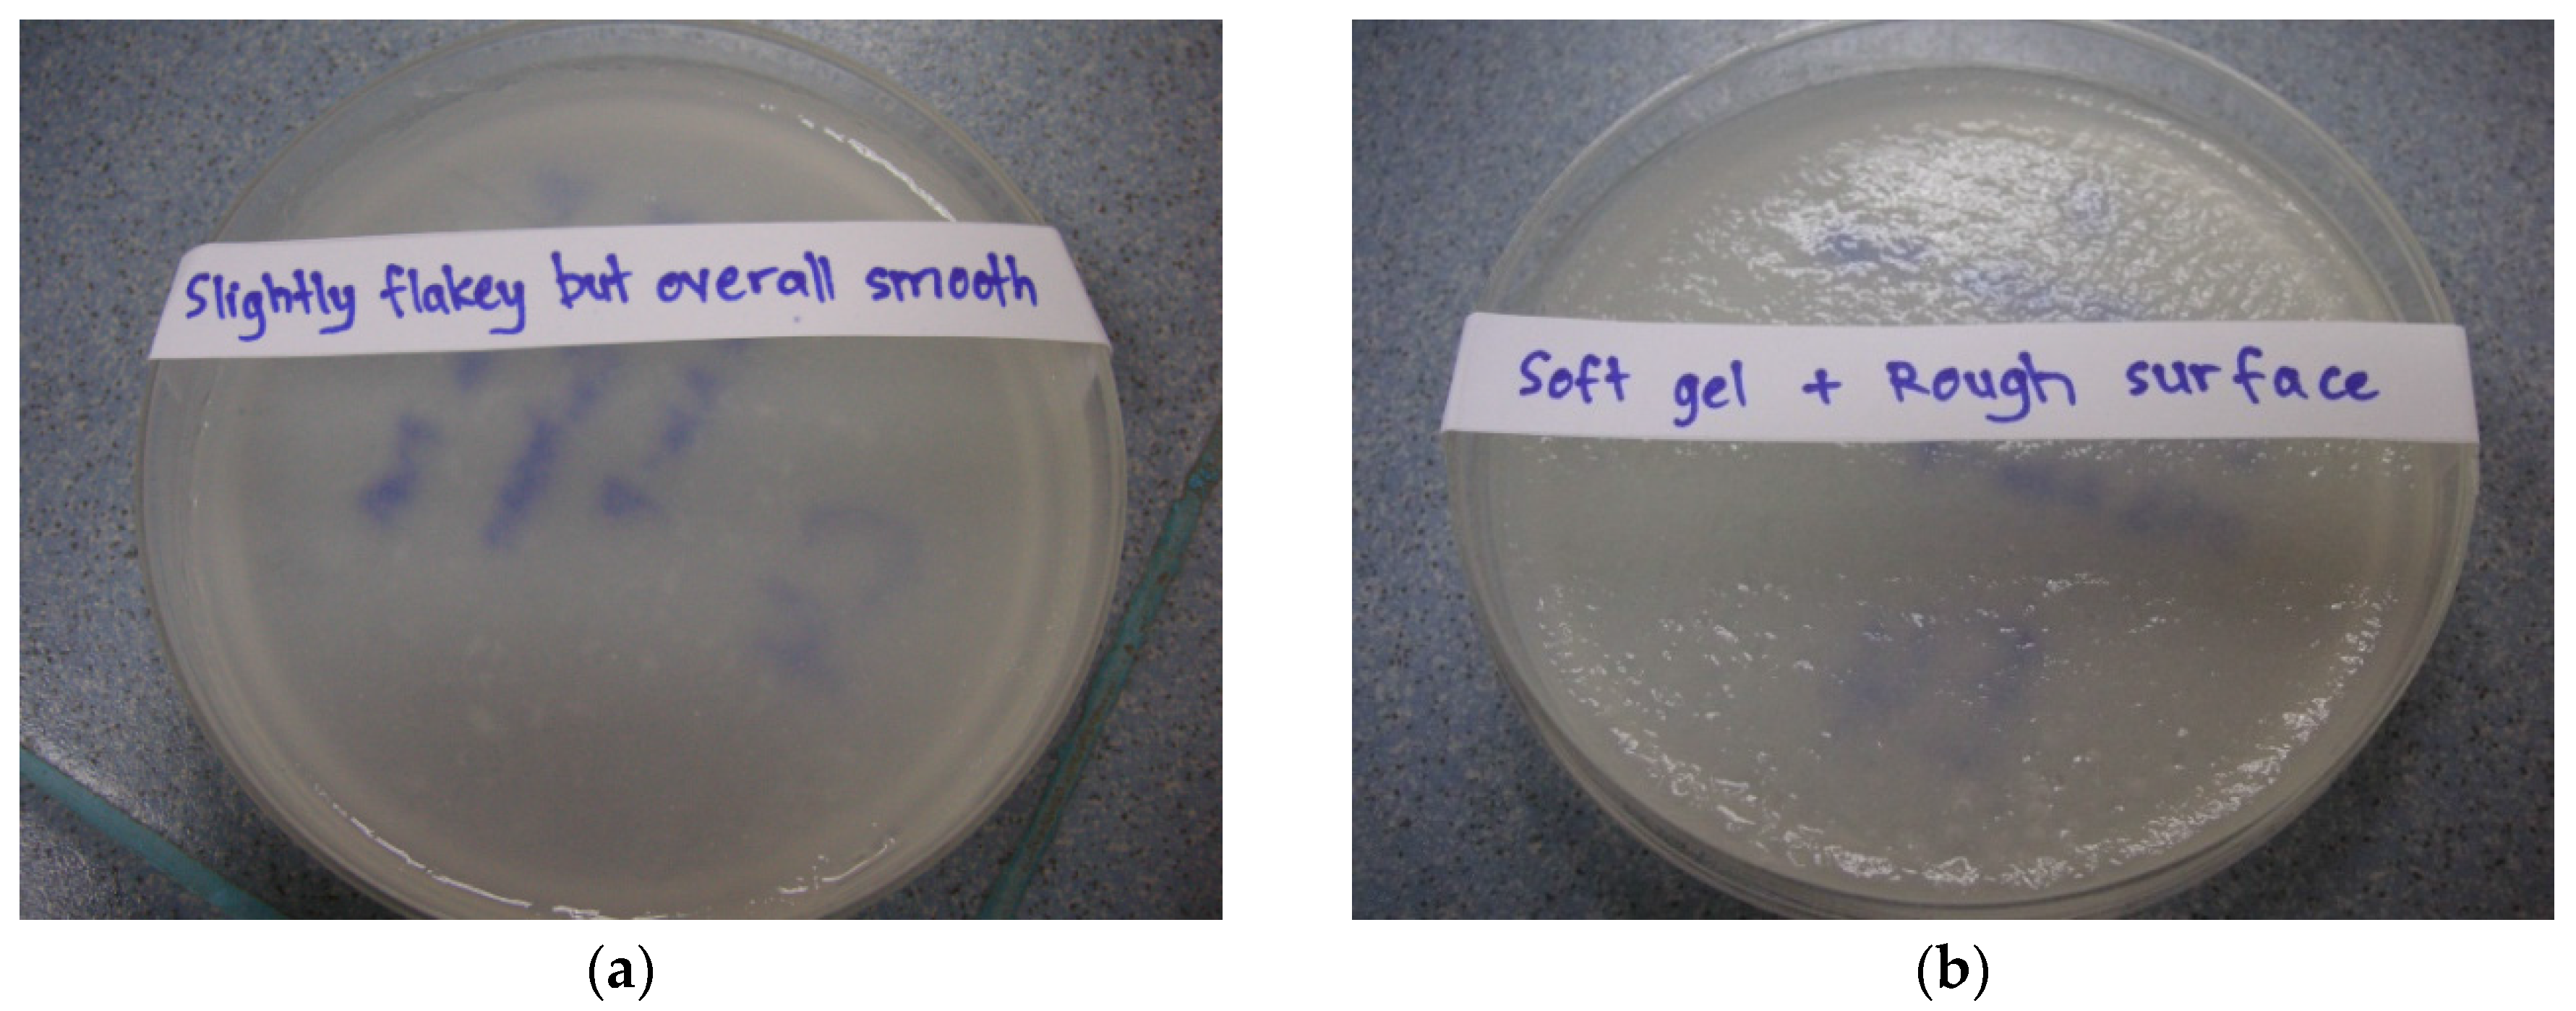
Medicines 03 00008 g001a 1024
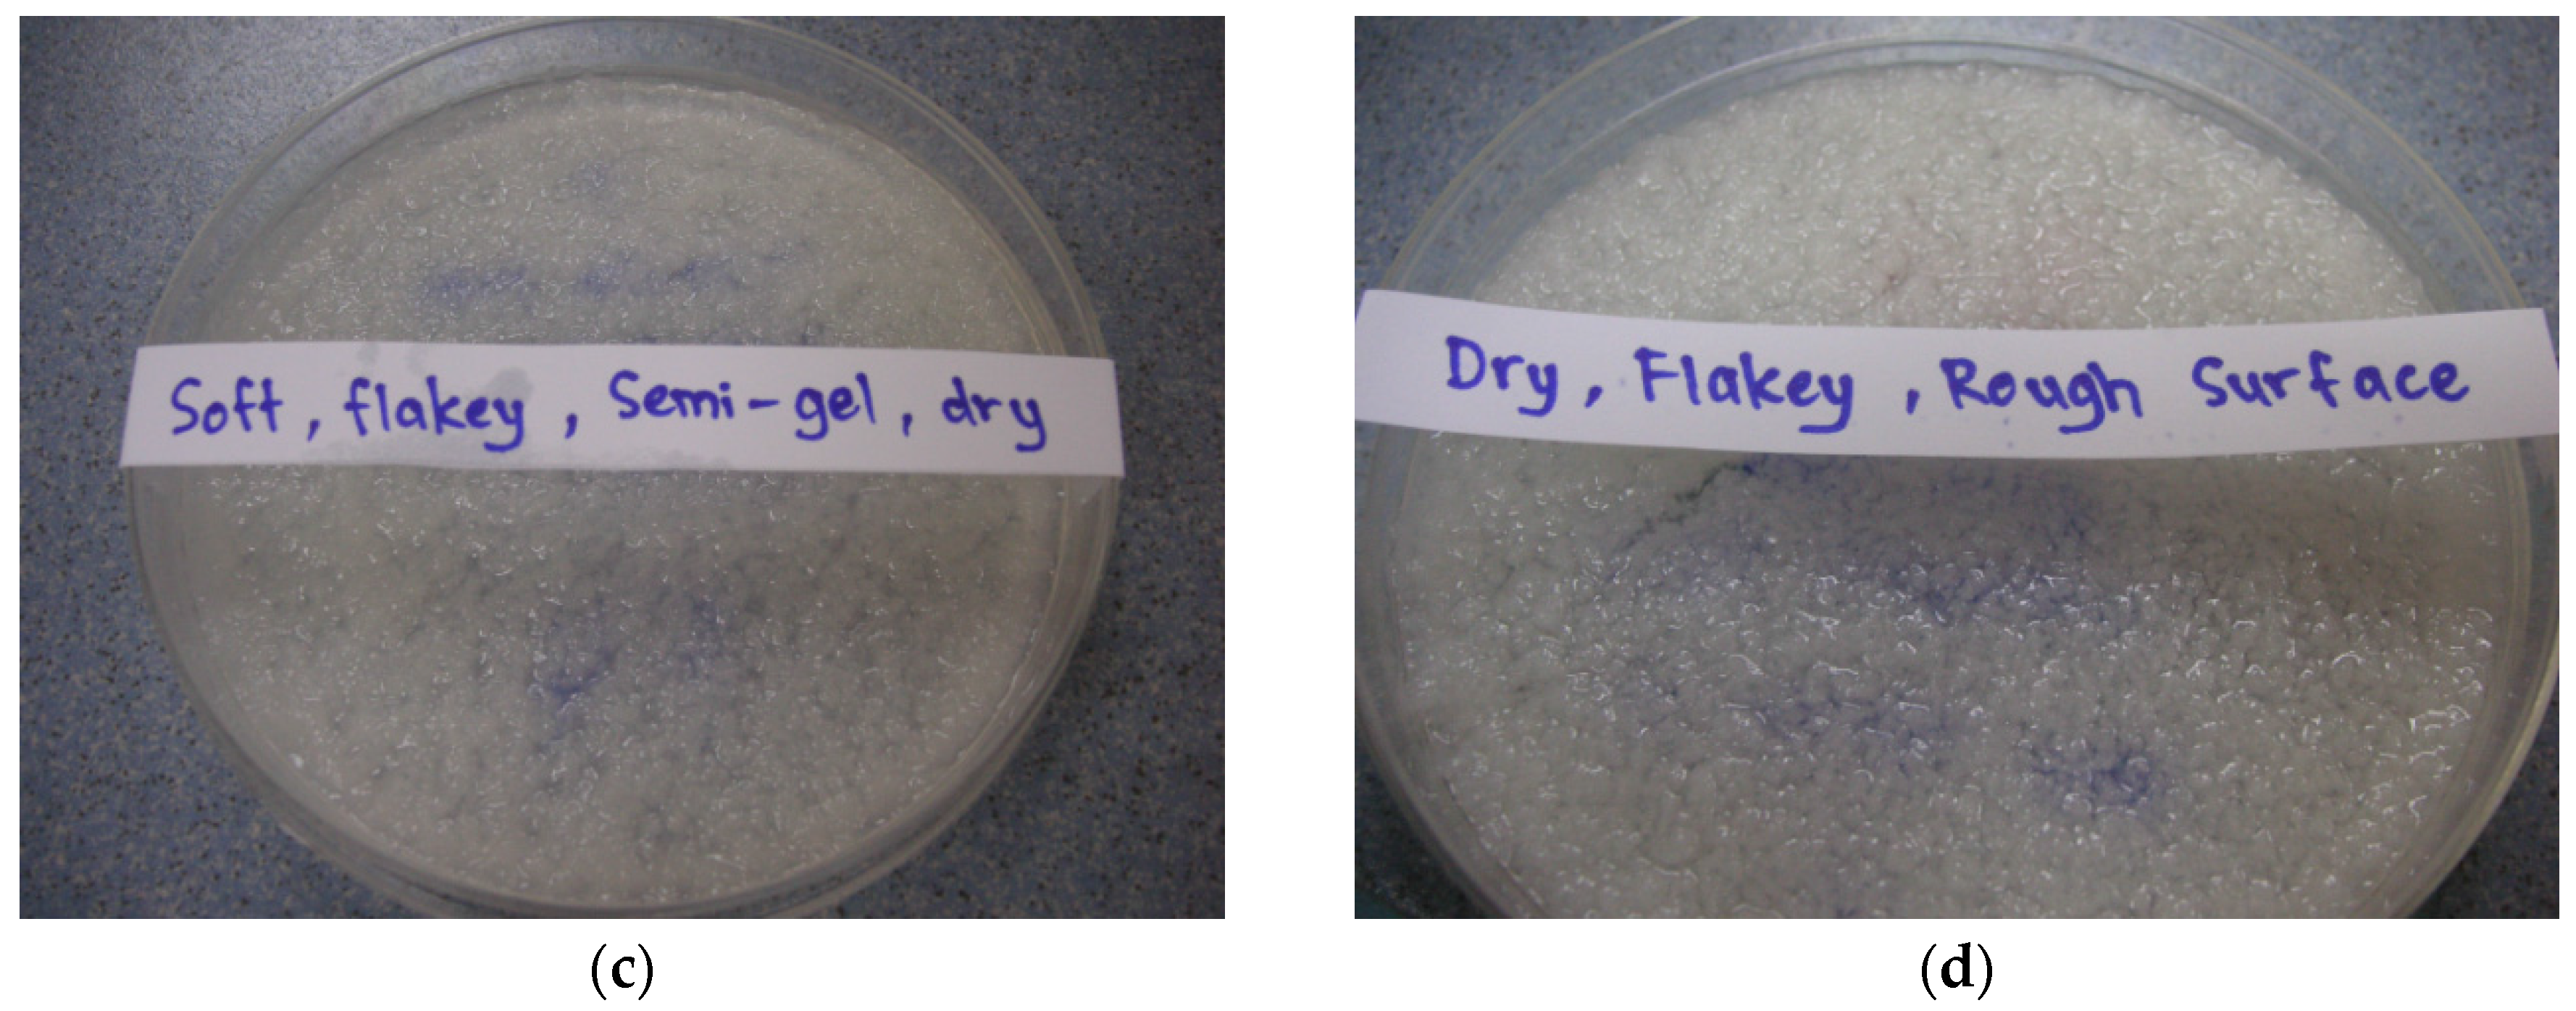
Medicines 03 00008 g001b 1024

3.2. Cumulative Chitosan and Monoterpene Release after 24 h Incubation
The release mechanism of chitosan and monoterpene (TTO) from hydrogels was investigated as a function of hydrogel degradation.
Figure 2 shows the release profiles of low-viscosity chitosan (
Figure 2A) and medium-viscosity chitosan (
Figure 2B) of hydrogel formulations containing 35% TTO: 65% PVA (10%
w/
v) emulsion. The release profiles of chitosan from formulations containing 50% TTO: 50% PVA (10%
w/
v) are shown in
Figure 2C. Similarly, the monoterpene release profiles from the respective hydrogel formulations are shown in
Figure 3.
Low-viscosity chitosan formulations showed chitosan release was between 9.72 × 10
−2 to 3.99 × 10
−1 %/mL at 24 h post-incubation (
Figure 2A). Comparatively, the amount of monoterpene release was fairly similar,
i.e., 2.53 × 10
−1 to 3.52 × 10
−1 %/mL (
Figure 3A). Results showed that lower-viscosity hydrogels and those formulated using PVA
13-23 (to emulsify the TTO prior to encapsulation) eroded at a higher rate (more chitosan released). The hydrogels formulated with PVA
13-23 and chitosan
L1.25 released 3.99 × 10
−1 %/mL compared to 2.07 × 10
−1 %/mL in gel formulated using chitosan
L2.5. Similarly, in hydrogels formulated with PVA
31-50, stability was also improved in gels formulated with chitosan
L2.5, resulting in 9.72 × 10
−2 %/mL chitosan release compared to 2.99 × 10
−1 %/mL in the gel formulated using chitosan
L1.25.
The trend of chitosan and monoterpene release from hydrogels formulated with medium-viscosity chitosan differs from the low-viscosity hydrogels. Results in
Figure 2B and
Figure 3B showed that chitosan
M1.25 formulations gradually released both chitosan and monoterpene over time. The formulation having a higher volume of 25%
w/
v Na-P (formulation C
M1.25PVA
13-23) displayed better stability properties,
i.e., low chitosan release (low erosion) with slow release of monoterpene. In contrast, formulations with chitosan
M2.5 showed a steep increase in chitosan release between 5 and 7.5 h post-incubation, resulting in the higher final amount released. Although the gels formulated with chitosan
M2.5 are considered to be more stable, those formulated with PVA
13-23 (formulation C
M2.5PVA
13-23) may be more prone to erosion due to the lower chitosan:Na-P ratio, resulting in weaker crosslinking. Similarly, the stability of the gels may also be compromised by the chitosan-PVA chain entanglement interaction. Hence, despite the higher chitosan:Na-P ratio, the gels formulated with PVA
31-50 (formulation C
M2.5PVA
31-50) appear to be less stable (greater chitosan erosion) due to the dissociation of the chitosan-PVA interaction. Consequently, this also resulted in higher monoterpene release, despite the more viscous properties of these formulations within the group.
When formulating medium-viscosity hydrogels with 50% TTO:50% PVA
v/
v, there were observable changes in the chitosan and monoterpene release profiles (
Figure 2C and
Figure 3C). The overall chitosan release from the formulations was lower when compared to the formulations in
Figure 2B. All formulations showed gradual increase of chitosan release over time, except formulation C
M1.25PVA
31-50 in
Figure 2C, which showed a steep increase between 4 and 6 h post-incubation.
Similar to the other formulations, increasing crosslinking along with increased viscosity improves hydrogel stability. These gels (C
M1.25PVA
13-23 and C
M2.5PVA
31-50 in
Figure 3C) showed a gradual increase in monoterpene release up to 5.65 × 10
−1 %/mL and 4.95 × 10
−1 %/mL, respectively. On the other hand, monoterpene release in the formulations having a lower ratio of chitosan:Na-P (less viscous) was between 7.65 × 10
−2 and 1.19 × 10
−1 %/mL. When monoterpene release for hydrogel formulations was analysed with zero order, first order, Higuchi and Korsmeyer-Peppas equations [
40], the results indicated that monoterpene release from the all the hydrogel formulations, except formulation C
M1.25PVA
13-23, follows the zero order release with a correlation coefficient of R > 0.97,
i.e., release of monoterpene was constant over time [
40]. The correlation coefficients for the other models (first order release, Korsmeyers-Peppas and Higuchi models) were all <0.97 (
Table 3). Based on the mathematical modelling, the release profile of formulation C
M1.25PVA
13-23 fits the Higuichi equation (R
2 > 0.97); hence, the monoterpene was released via a diffusional process according to Fick’s law [
40].
Preferably, TTO-hydrogel formulations should be tailored to have lower chitosan release along with more controlled monoterpene release, thus indicating increased formulation stability with sustained delivery of TTO to maintain antimicrobial efficacy. It is evident that there are many factors which may influence the viscosity and properties of each formulation.
3.3. Well Diffusion Assay of Hydrogels Containing TTO and/or Ag+
The results from the well diffusion assay showed antimicrobial activity in the presence of the agents both singly and in combination. Increasing the viscosity of chitosan from low to high effectively increases the respective molecular weight and polymeric chain length [
42], which results in potentially greater inter-chain entanglement, hence affecting its viscosity and ability to release the antimicrobial agents. The antimicrobial activity of the formulations will be discussed separately based on the type of agent and chitosan viscosity.
The effect of TTO-hydrogel (low viscosity) formulations follows an order of sensitivity similar to that of the minimum lethal concentration (MLC) reported in Low
et al. (2011) [
43] for free TTO,
i.e.,
C. albicans >
S. aureus ≥
P. aeruginosa (
Figure 4A). Results showed little changes in the zones of inhibition (ZOI) against
P. aeruginosa, possibly due to the higher tolerance of
P. aeruginosa to TTO. In
Figure 4A, the formulations C
L1.25(17)Na-P
25(17)TTO
35(8)-C
L2.5(7)Na-P
25(9)TTO
35(5) vary with increasing viscosity and amount of crosslinker which can improve gel stability. This resulted in more stable TTO hydrogels which can entrap more of the essential oil; the improved antimicrobial activity is observed by an increased ZOI for microorganisms with higher TTO sensitivity, e.g.,
C. albicans. Despite increased formulation stability (C
L1.25(17)Na-P
25(17)TTO
35(8)-C
L2.5(7)Na-P
25(9)TTO
35(5)), the ZOI for less sensitive microorganisms, e.g.,
P. aeruginosa and
S. aureus, has not been significantly affected (
p > 0.05). This may be due to the slower rate of TTO release (from more stable hydrogels) which limits the availability of the agent at microbiocidal concentrations, and thus the ZOI for less sensitive microorganisms are not affected. Conversely, formulation C
L2.5(10)Na-P
50(7)TTO
35(4) had the lowest chitosan: Na-P ratio which makes it less stable and more prone to faster erosion and drug release, resulting in a burst release of TTO which leads to a higher ZOI after 24 h incubation. Such immediate burst release with concomitant rapid hydrogel erosion is not particularly useful when treating wounds with heavy microbial loads. Formulations therefore need to be optimised to reduce the rate of erosion and degradation of the hydrogel whilst maintaining prolonged delivery of agents at microbiocidal concentrations.
Results from
Figure 4B did not show significant ZOI changes with increasing stability (C
M2.5(11.75)Na-P
25(4.25)TTO
35(5)-C
M1.25(12)Na-P
50(5)TTO
35(4)) against
P. aeruginosa. The ZOI in hydrogels C
M2.5(12.5)Na-P
50(2.5)TTO
35(4) and C
M1.25(12)Na-P
50(5)TTO
35(4) follows the MLC sensitivity trend of
C. albicans >
S. aureus >
P. aeruginosa. However, the extent of antimicrobial activity, especially against the more sensitive
C. albicans, is lower than those formulated with low-viscosity chitosan (C
L2.5(10)Na-P
50(7)TTO
35(4)-C
L2.5(7)Na-P
25(9)TTO
35(5)). This reduce in antimicrobial activity is probably due to the overall increase in chitosan chain length (moving from low to medium viscosity), which potentially increases inter-chain entanglement, hence retarding the ability of TTO diffusion and thereby reducing the amount released from the hydrogel structure. Within this group, formulation C
M2.5(12.5)Na-P
50(2.5)TTO
35(4) (lowest chitosan:Na-P ratio) forms a less stable hydrogel with a higher rate of erosion; the reduced crosslinking also contributes to a less stable gel network to maximise TTO:PVA encapsulation by allowing chain entanglement interactions between PVA and chitosan. As a result, TTO escape from the hydrogel may again follow a burst release profile and increase the ZOI for
C. albicans and
S. aureus. However, the concentration was insufficient to show a clear ZOI for
P. aeruginosa, although there was an observed zone of restricted growth with an average diameter of 30.33 mm. Formulations C
M2.5(12)Na-P
25(5)TTO
35(4) and C
M1.25(12)Na-P
50(5)TTO
35(4) are more stable due to their increased viscosity (there is more chitosan in the formulation which is not diluted by the addition of aqueous Na-P). Despite having the same chitosan:Na-P ratio, the antimicrobial performance of C
M2.5(12)Na-P
25(5)TTO
35(4) and C
M1.25(12)Na-P
50(5)TTO
35(4) was different. This may be due to the variations in Na-P concentration, which can alter crosslinking and viscosity of hydrogels (C
M2.5(12)Na-P
25(5)TTO
35(4) formulated using 25%
w/
v Na-P, C
M1.25(12)Na-P
50(5)TTO
35(4) formulated using 50% Na-P). Such properties include both the viscosity of the various chitosan solutions and the ability of oppositely charged crosslinking phosphate anions to diffuse into the solution and form an electrostatically crosslinked semi-solid structure. The order of sensitivity in formulation C
M2.5(11.75)Na-P
25(4.25)TTO
35(5) was altered to
S. aureus >
C. albicans >
P. aeruginosa, which could have resulted from the higher concentration of TTO present in the hydrogels.
Figure 4C showed that antimicrobial activity of hydrogels formulated with high-viscosity chitosan against
C. albicans increased with increasing viscosity. The ZOI against
S. aureus remained fairly consistent, possibly due to the increased gel stability and higher encapsulation of TTO and its components, which are subsequently available for release. Formulation C
H2.5(10)Na-P
50(1)TTO
35(4)PVA
10(6)-C
H2.5(22)Na-P
50(7)TTO
35(8)PVA
10(5) showed no clear ZOI against
P. aeruginosa; however, similar to formulation C
M1.25(12)Na-P
50(5)TTO
35(4), there was an insufficient concentration of TTO to result in a clear ZOI and zones of restricted growth with average diameters of 13.5 mm (C
H2.5(10)Na-P
50(1)TTO
35(4)PVA
10(6)), 33.0 mm (C
H1.25(13)Na-P
50(4)TTO
35(4)) and 30.667 mm (C
H2.5(22)Na-P
50(7)TTO
35(8)PVA
10(5)) were observed. Formulation C
H1.25(10)Na-P
25(7)TTO
35(4) was shown to have a ZOI against
P. aeruginosa. The results in
Figure 4 indicated that changes in hydrogel composition can affect their respective antimicrobial activities, possibly due to alterations in physicochemical properties of the gels.
The activity of Ag
+ hydrogels will be discussed based on the viscosity of chitosan and concentration of AgNO
3 because it has electrostatic crosslinking properties that affect the stability of the resultant hydrogels as well as their antimicrobial activity. In Ag
+ hydrogels, the order of sensitivity also follows the MLC order of Ag
+ reported in Low
et al., 2011 [
43],
i.e.,
C. albicans >
P. aeruginosa ≥
S. aureus (
Figure 5), when the concentration of Ag
+ is >0.2117%
w/
v. However, when the concentration is ≤0.2117%
w/
v Ag
+ (formulation C
L2.5(28)Ag
2(7)PVA
10(7), C
L2.5(10.5)Ag
0.75(7)PVA
10(3.5), C
M2.5(10)Ag
1(5)PVA
10(6), C
M2.5(7)Ag
1(7)PVA
10(7) and C
H2.5(14)Ag
2(2)PVA
10(5)), the order changes to
P. aeruginosa >
S. aureus ≥
C. albicans. Experimental results also showed that as Ag
+ diffuses into the MEA, a precipitate is formed in the agar. This can reduce the bioavailability of Ag
+ against
C. albicans, resulting in a shift in the order of sensitivity. Despite its role as a crosslinker, the antimicrobial activity of Ag
+ is not affected if there are sufficient metal ions available for release from the hydrogel matrix (refer to
Figure 5).
In
Figure 5A, formulations with >0.2117%
w/
v Ag
+ (C
L1.25(9)Ag
2(12)-C
L1.25(8)Ag
2(13)) all showed a ZOI against
C. albicans, unlike formulations C
L2.5(28)Ag
2(7)PVA
10(7) and C
L2.5(10.5)Ag
0.75(7)PVA
10(3.5). The observed ZOI was not influenced by the small increase in Ag
+ concentration from 0.635% to 0.786%
w/
v. All formulations showed a ZOI against
P. aeruginosa and
S. aureus. The increase in Ag
+ from C
L1.25(9)Ag
2(12) to C
L1.25(8)Ag
2(13) showed a gradual increase in ZOI, although this increase was not significant (
p > 0.05). This may be due to the higher free Ag
+ MLC of
P. aeruginosa (1.59 × 10
−3 %
w/
v) and
S. aureus (5.08 × 10
−3 %
w/
v) compared to
C. albicans (6.35 × 10
−4 %
w/
v) [
43]. Medium-viscosity chitosan hydrogels (
Figure 5B) showed relatively similar ZOI when compared to those in
Figure 5A with comparable amounts of Ag
+ (C
L2.5(28)Ag
2(7)PVA
10(7) and C
M2.5(10)Ag
1(5)PVA
10(6); C
L2.5(10.5)Ag
0.75(7)PVA
10(3.5) and C
M2.5(7)Ag
1(7)PVA
10(7)). Formulations C
M1.25(22)Ag
2(20) and C
M1.25(10.5)Ag
2(10.5) also showed a similar order of sensitivity as observed in C
L1.25(9)Ag
2(12). The increased viscosity in C
M1.25(22)Ag
2(20) and C
M1.25(10.5)Ag
2(10.5) may increase entrapment of Ag
+ within the hydrogel, leading to a slight increase in the ZOI against
P. aeruginosa and
S. aureus. However, this is not observed in
C. albicans, as the slower release lowered the availability of Ag
+, making it difficult to overcome the reaction with MEA and to express antimicrobial activity.
A similar trend applies when hydrogels formulated with high-viscosity chitosan were used, e.g., formulation C
H1.25(14)Ag
2(10.5) in
Figure 5C. The higher viscosity of hydrogels in
Figure 5C altered the order of sensitivity to
P. aeruginosa being most sensitive, followed by
C. albicans and
S. aureus. Disregarding
C. albicans, this trend of sensitivity showed similarities to the results obtained from the MLC of free Ag
+ [
43]. In addition to the high viscosity, the interaction between the Ag
+ and MEA makes it more difficult to monitor the actual extent of antimicrobial activity against
C. albicans.
According to
Figure 6, the order of sensitivity generally follows the MLC response for free agents reported in Low
et al., 2011 [
43],
i.e.,
C. albicans >
P. aeruginosa >
S. aureus, for low- and medium-viscosity but not high-viscosity chitosan hydrogels. Formulation C
L1.25(12)TTO-Ag
20-0.5(3)Na-P
25(1)PVA
10(5)-C
L1.25(9.5)TTO-Ag
20-1(11.5) (
Figure 6A) shows that the antimicrobial activity of the hydrogels is dependent on the viscosity and Ag
+ content in the system. Higher viscosity with increased Ag
+ forms gels with better stability for entrapment of agents and reduces burst release of agents via erosion. Nevertheless, such properties may allow controlled release to be achieved for sustained antimicrobial activity against less sensitive microorganisms. Small increments in ZOI of the microorganisms were observed as the concentration of agents increased (formulations C
L1.25(12)TTO-Ag
20-0.5(3)Na-P
25(1)PVA
10(5)-C
L1.25(9.5)TTO-Ag
20-1(11.5), except C
L1.25(12)TTO-Ag
20-0.5(3)Na-P
25(1)PVA
10(5) against
C. albicans). The lower Ag
+ content in C
L1.25(12)TTO-Ag
20-0.5(3)Na-P
25(1)PVA
10(5) may reduce crosslinking to enable a faster release of TTO. Thus, the observed higher ZOI may be due to
C. albicans having higher sensitivity to TTO. Similarly, this was also observed in the ZOI of formulations C
M2.5(11)TTO-Ag
20-1(6)PVA
10(4), C
M2.5(7)TTO-Ag
20-1(7)PVA
10(7) and C
M1.25(10)TTO-Ag
20-1(11) (
Figure 6B) against
C. albicans. The higher concentration of TTO in formulation C
M2.5(7)TTO-Ag
20-1(7)PVA
10(7) (0.1058%
w/
v Ag
+ and 13.333%
v/
v TTO) resulted in the higher
C. albicans ZOI compared to a relatively similar counterpart, formulation C
M2.5(11)TTO-Ag
20-1(6)PVA
10(4) (0.1814%
w/
v Ag
+ and 5.7143%
v/
v TTO). The ZOI of
S. aureus and
P. aeruginosa remained fairly consistent between formulations C
M1.25(12)TTO-Ag
20-0.5(3)Na-P
25(0.75)PVA
10(5.25)- C
M1.25(10)TTO-Ag
20-1(11).
High-viscosity chitosan hydrogels (
Figure 6C) showed slight variation from the MLC data. The order of sensitivity is
P. aeruginosa ≥
C. albicans >
S. aureus. Similar to all the other formulations, the overall viscosity of the system, the crosslinking capacity of Ag
+ and the amount of TTO affect the antimicrobial activity of the formulations.
Nevertheless, hydrogels containing both TTO and Ag+ managed to maintain their antimicrobial activity despite having agent concentrations lower than those in TTO or Ag+ hydrogels. For example, formulation CH2.5(21.5)TTO-Ag20-1(3.5)PVA10(14), containing 0.0570% w/v Ag+ and 1.795% v/v TTO, maintained antimicrobial activity when compared to similar formulations (e.g., CH2.5(14)Ag2(2)PVA10(5) containing 0.0605% w/v Ag+, and CH2.5(10)Na-P50(1)TTO35(4)PVA10(6) containing 6.6667% v/v TTO). At low concentrations of Ag+, formulation CH2.5(14)Ag2(2)PVA10(5) did not show a clear ZOI against C. albicans, while formulation CH2.5(10)Na-P50(1)TTO35(4)PVA10(6) did not show a clear ZOI against P. aeruginosa, despite having higher TTO content. The ZOI observed for S. aureus remained fairly consistent when comparing the hydrogels formulated with varying chitosan viscosity. The maintenance of activity when using both agents at lower concentrations demonstrates the feasibility of using combined agents at lower effective concentrations.
Incorporation of TTO and/or Ag
+ into chitosan hydrogels demonstrated the possibility of maintaining antimicrobial activity when using a delivery system. The capacity and performance of antimicrobial agents varies depending on the type of dressing and wound. For the treatment of moist wounds, e.g., ulcers, the absorptive properties of hydrogels make them a better option compared to non-absorptive dressings such as gauzes. Research indicated that there is no single dressing that can produce the optimum microenvironment for all wounds [
44], thus the characteristics of formulations and delivery systems need to be tailored to suit the wound site.
Factors such as the differences in physicochemical properties of the hydrogels, including chitosan viscosity, concentration of the crosslinker (Na-P or AgNO3) and the amount of available antimicrobial agent (Ag+ or TTO), may result in the observed varying order of sensitivity between formulations. Low-, medium- and high-viscosity chitosans derive their rheological properties from the increasing chain length of the polymer. Within each of these groups the concentration of chitosan and the degree of crosslinking also influence viscosity. In addition, increasing the amount of Na-P improves crosslinking and increases hydrogel stability.
Changes in TTO composition in the hydrogels may occur due to the loss of volatile TTO components during the gel setting period. The availability of Ag+ varies according to the concentration required for crosslinking (AgNO3 donates the anionic crosslinking nitrate group) and the release of Ag+ from the hydrogel.
Encapsulation of broad spectrum antimicrobial agents (TTO and/or Ag
+) into hydrogel-based formulations may be a feasible option to enhance biodistribution and biological activity of the agents. Despite the effectiveness of combined treatments, the toxicity of individual agents towards human host cells should also be carefully considered. Although toxicity or irritancy are less likely to occur, various reports of toxicity associated with the misuse/overuse of TTO [
12,
45], Ag
+ and silver-containing products have been discussed [
10,
26,
28]. Thus, it is important to find an effective lower combination ratio of TTO and Ag
+ concentrations to avoid toxicity issues whilst maintaining antimicrobial properties. In this investigation, PVA was used to emulsify TTO to form an oil-in-water emulsion. This will allow more efficient encapsulation into the hydrogels, reducing loss and degradation of volatile components which may affect the oil’s therapeutic activity [
37,
44]. Emulsifying essential oils can also improve hydrophobic and hydrophilic component distribution due to reduced droplet size [
44]. The release kinetics of agents incorporated into chitosan gels may be influenced by factors such as the morphology, size, density, extent of crosslinking, gel formulation ability and swelling of the chitosan-based hydrogel [
46].